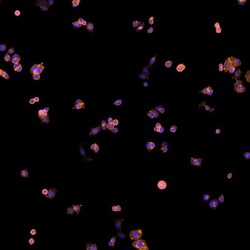
Invitrogen Goat anti-Human IgG (H+L) Cross-Adsorbed Secondary Antibody,

Få mere at vide
Invitrogen™ Goat anti-Human IgG (H+L) Cross-Adsorbed Secondary Antibody, Alexa Fluor™ Plus 594
Goat Polyclonal Secondary Antibody
Brand: Invitrogen™ A48278
Beskrivelse
To minimize cross-reactivity, the goat anti-human IgG whole antibodies have been cross-adsorbed against serum proteins from bovine, mouse, and rabbit. Cross-adsorption or pre-adsorption is a purification step to increase specificity of the antibody resulting in less background staining and cross-reactivity. The secondary antibody solution is passed through a column matrix containing immobilized serum proteins from potentially cross-reactive species. Only the nonspecific-binding secondary antibodies are captured in the column, and the highly specific secondaries flow through. Further passages through additional columns result in highly cross-adsorbed preparations of secondary antibody. The benefits of these extra steps are apparent in multiplexing/multicolor-staining experiments where there is potential cross-reactivity with other primary antibodies or in tissue/cell fluorescent staining experiments where there may be the presence of endogenous immunoglobulins. Using conjugate solutions: Centrifuge the protein conjugate solution briefly in a microcentrifuge before use; add only the supernatant to the experiment. This step will help eliminate any protein aggregates that may have formed during storage, thereby reducing nonspecific background staining. Because staining protocols vary with application, the appropriate dilution of antibody should be determined empirically. Specificity: This antibody binds to heavy chains on human IgG and light chains on all human immunoglobulins...
Anti-Human secondary antibodies are affinity-purified antibodies with well-characterized specificity for human immunoglobulins and are useful in the detection, sorting or purification of its specified target. Secondary antibodies offer increased versatility enabling users to use many detection systems (e.g. HRP, AP, fluorescence). They can also provide greater sensitivity through signal amplification as multiple secondary antibodies can bind to a single primary antibody. Most commonly, secondary antibodies are generated by immunizing the host animal with a pooled population of immunoglobulins from the target species and can be further purified and modified (i.e. immunoaffinity chromatography, antibody fragmentation, label conjugation, etc.) to generate highly specific reagents.
Tekniske data
| Human IgG (H+L) Cross-Adsorbed | |
| Polyclonal | |
| Alexa Fluor Plus 594 | |
| Goat | |
| Affinity chromatography | |
| RUO | |
| Human | |
| Secondary Antibody | |
| IgG |
| Immunocytochemistry | |
| 2 mg/mL | |
| Proprietary buffer with 0.016% Methylisothiazolone, 0.016% Bromonitrodioxane; pH 6.5 | |
| Gamma Immunoglobins Heavy and Light chains. | |
| 1 mg | |
| Secondary | |
| 4°C, store in dark | |
| Liquid |
Dit input er vigtigt for os. Udfyld denne formular for at give feedback relateret til indholdet på dette produkt.